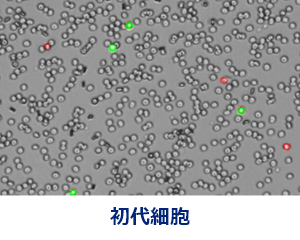
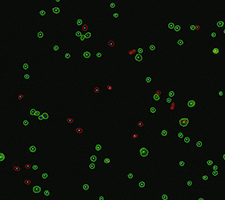

スライドが要らない自動セルカウンター
CellDrop シリーズ

セルカウンターはスライドを使わない時代に
微量分光光度計と同じ方法で測定できる自動セルカウンター
CellDropは研究者の投票で決まるSelectScienceの年間最優秀製品賞と持続的評価の高い製品に与えられるプラチナシールを受賞しています。また、環境にやさしい製品に与えられるMy Green labのACT Labelを取得しています。
これまでの自動セルカウンターは、その測定にディスポーサブルスライド(使い捨てスライド)を使用するのが当たり前でした。
そのため、細胞カウントあるいは細胞生存率解析に多くの消耗品代を費やす必要があり、プラスチック廃棄物の量も多大でした。
測定の際には、スライドにサンプルを入れて、そのスライドをセルカウンターに挿入する必要があり、多くのサンプルの測定では手間になることもありました。
CellDropシリーズは、セルカウンターに微量分光光度計の原理を応用することで、その課題を解決しました。
独自のDirectPipette Technology(特許取得済)により、使い捨てスライドを使用せず、細胞懸濁液を装置に直接のせるだけで測定を開始できます。測定後はサンプル台を拭くだけですぐに次の測定が可能です。
測定時間はわずか3秒(蛍光は8.5秒)
迅速に細胞密度と生存率を知ることができます。
さらに、高い画像認識技術とフレキシブルなパラメーター設定により、目視によるマニュアルカウントに匹敵する細胞認識を実現することができます。
従来のセルカウンターにはない便利さ
簡単3ステップ測定

➊ サンプルをロードする
細胞懸濁液を装置のサンプルチャンバーに直接ロードします。サンプルはアームの右からでも左からでも入れることができます。左利きの方も不自由しない設計です。

❷ カウントする
Countボタンを押すと装置が細胞を自動でカウントします。測定時間は明視野で約3秒、蛍光で約8.5秒です。フォーカスは自動フォーカスとマニュアルフォーカスを選べます。

❸ サンプル台を拭く
アームを上にあげて、乾いたラボワイプで表面を拭きます。サンプル台は光学サファイヤのため傷がつきません。拭いたらすぐに次のサンプルをロードできます。
DirectPipette テクノロジー
「のせて」「測って」「拭くだけ」を実現させているのが、CellDrop 自動セルカウンターだけが持つ独自のDirectPipette テクノロジー(特許取得)です。
サンプルチャンバー
- 上下の永久的に使用できる光学サファイヤ表面
- 細胞懸濁液を上下の間に表面張力でサンドイッチして保持
- ソフトウェアで3段階のチャンバーの高さを選択可能
- 幅広いダイナミックレンジ:7x102 ~ 2.5x107 cells/mL
- 測定可能な細胞サイズ:4 – 400 µm(倍率4x)、2 – 20 µm(倍率10x)

| 従来のセルカウンター | CellDrop | |
|---|---|---|
| スライド | 必要 | 不要 |
| 測定方法 | スライドにサンプルを注入 | サンプルを直接のせて、測って、拭くだけ |
| 測定時間 | 約10~30秒 | 約3~8.5秒 |
| 測定濃度 | 1×104~ 107 cells/mL | *7×102~2.5×107cells/mL |
*CellDrop BF, FLiの場合
CellDropシリーズ
![]() |
![]() |
![]() |
![]() |
|
| CellDrop BF | CellDrop BFx | CellDrop FLi | CellDrop FLxi | |
| 明視野(トリパンブルー法) | ● | ● | ● | ● |
| 蛍光(AO/PI法) | ● | ● | ||
| GFP | ● | ● | ||
| 倍率 | 4倍 | 10倍 | 4倍 | 10倍 |
| 細胞サイズ | 4 - 400 µm | 2 - 20 µm | 4 - 400 µm | 2 - 20 µm |
| 機械学習ベースのアプリ | ● | ● | ||
| 色 | 白 / 緑 | 白 / 緑 | 白 / 緑 | 白 / 緑 |
4つの測定オプション
CellDrop は、あらゆるラボのご予算、スループット等に合うようにさまざまな測定オプションをご用意しております。
測定オプションはいつでも追加、変更可能です。

これまでの自動セルカウンターに満足されていますか?

自動セルカウンターを購入したものの使用していない、あるいはセルカウンターのデモを行ったがどれも購入しなかった、そんな声をよくお聞きします。
その理由は何でしょう?
自動セルカウンターは消耗品コストが高いから?スライドレスで測定できるCellDropはスライド代が不要です。
細胞をちゃんと認識してくれないから? 目で見て数えたほうが正確だから? 目視と同じ結果が出ないから?
CellDropを試してみませんか!
優れた細胞認識性能
CellDropのソフトウェアは画像解析の能力に秀でています。これまでお使いのセルカウンター(これまでデモで試したセルカウンター)でうまくいかなかったサンプルや細胞でも、CellDropなら正確にカウントできる可能性があります。

凝集した細胞を分けて認識
細胞の中には凝集塊を作りやすい性質のものがあります。CellDropはパラメーターを適切に設定することで、クラスター化した細胞をそれぞれ分けてカウントさせることができます。

歪な形の細胞の認識
円形ではなく変形した形の細胞をカウントしたいときもあります。CellDropではIrregular Cell Modeを使用することで、そのような細胞の認識率を向上させることができます。

小さい細胞の認識
リンパ球や酵母など小さい細胞の認識は従来のセルカウンターでは難しいことがありました。CellDropではSmall Cell Modeを使用することで、小さい細胞の認識を向上できます。
蛍光染色によるセルカウントと細胞生死判定も可能
CellDrop 自動セルカウンターには、明視野測定専用のCellDrop BFと、明視野測定に加えて蛍光測定も可能なCellDrop FLの2モデルがございます。蛍光染色によるセルカウントは明視野法にはない利点がございます。
蛍光セルカウント法は、どのようなサンプルや細胞でも明視野カウントに比べて細胞の認識と生死判定が明確というメリットがありますが、特に下記のような場合に推奨されます。
- デブリス(細胞の残骸物)の多いサンプル(特に細胞と同じ大きさのデブリスが多いサンプル)
- 小さい細胞を数えたい
- 大きい細胞と小さい細胞が混在している
- 無核細胞が混在したサンプルから有核細胞をカウントしたい
- 細胞の中に明視野で見える構造物がある
- 核をカウントしたい
![]() 明視野(トリパンブルー法) |
![]() 蛍光(AO/PI法) |
|
| 生死判別 |
死細胞の細胞質が青く染色される 生細胞は染色されない |
生細胞の核が緑色蛍光(AO)で染色される 死細胞の核が赤色蛍光(PI)で染色される |
| 染色してからの時間の影響 | 染色後時間が経つと生細胞も染まってくる | 染色後の時間は影響しない |
| デブリス | 誤ってカウントされやすい | カウントされない |
| 無核細胞 | 赤血球などの無核細胞もカウントされる | 無核細胞はカウントされない |
| 核のカウント | できない | できる |
※ AO=Acridine Orange(アクリジンオレンジ)
※ PI=Propidium Iodide(ヨウ化プロピディウム)
様々な細胞やサンプルの測定に
CellDropは、セルラインだけでなく様々な動物細胞、酵母、昆虫細胞、藻類細胞、花粉などのカウントに使用することができます。
10x Genomics社のシングルセル解析やATAC-Seqのサンプル調整における核カウントにも多くのお客様にご使用いただいています。

実はスライドも使用できます

CellDropはスライドレスで測定することができますが、どうしても必要な時にはディスポーサブルスライドを使用した測定にも対応しています。
例えば感染性の高いサンプルで、グローブの上からでも触れるのが危ない、あるいは封じ込めが必要な場合などは、使い捨てスライドを使用することもできます。
一般的なディスポーサブル・カウンティングスライドに対応しています。
機能的なアプリソフトウェア
CellDropの操作は、装置前面のタッチパネルで行います。ラボグローブを着けたままでも快適にタッチ・スワイプ・ピンチの操作が可能です。
測定メソッド
明視野モデル(CellDrop BF)と明視野・蛍光モデル(CellDrop FL)で使用できる測定モードが異なります。
CellDrop BF / BFxの主なプリインストールアプリ

CellDrop FLi / FLxiの主なプリインストールアプリ

セルカウントを便利にするソフトウェア機能
● ホーム画面
ホーム画面には測定メソッドや様々な機能がアイコンで並んでいます。
アイコンをクリックして使用する測定メソッドを開きます。

● プレビュー
プレビュー画面でフォーカスを確認と調整を行います。
フォーカス調整はオートフォーカスとマニュアルフォーカスが可能です。

● 測定結果
測定結果の画面では左に数値データ、右に画像が表示されます。画像上でカウントされた細胞を確認いただけます。
- 全細胞数 / 生細胞数 / 死細胞数
- 細胞生存率%
- 平均直径
- 全細胞密度 / 生細胞密度 / 死細胞密度(cells/mL) など
※ 表示される数値データ項目は測定モードにより異なります。

● グラフ表示
測定結果を様々な形でグラフ表示することができます。
- 細胞サイズのヒストグラム
- クラスターサイズのヒストグラム
- 細胞生存率%
- GFPトランスフェクション効率% など
※ 表示できるグラフは測定モードにより異なります。

● ゲーティング
測定結果からヒストグラムを使用して、細胞サイズ(あるいは核サイズ)によるゲーティングを行っていただくことができます。
特定の細胞集団の結果に絞り込んだり、デブリスを結果から取り除くことに役立ちます。
ゲーティングに細胞数や細胞生存率などがすぐに再計算されて、結果に反映されます。
GFPモードではGFP強度ヒストグラムを用いてゲーティングが可能です。

● 計数パラメーターの調整と保存
細胞(核)のカウントのための各種のパラメーターを調整し、再計算させます。調整したパラメーターは保存して次回の測定以降に呼び出して使用できます。
- 希釈率
- 細胞あるいは核の直径の範囲(最小直径と最大直径)
- 細胞あるいは核の真円度
- 染色強度(シグナル強度)の閾値
- Small Cell ModeおよびIrregular Cell ModeのON/OFF

● 希釈率の計算
細胞数あるいは細胞密度を入力し、希釈後の懸濁液の量を指定することで、希釈の方法を自動計算します。
細胞継代やアッセイ前における希釈計算が苦手な方も安心の機能です。

測定結果の保存とエクスポート
測定結果は装置本体のSSDに自動保存され、データベースからいつでも閲覧することができます。
結果のエクスポートも様々な方法で可能です。PDFファイル、csvファイル、pngファイル(画像)をエクスポートできます。
☑ ネットワークホルダー
☑ USBメモリ
☑ 電子メール
☑ プリンター
バリデーションサービス
IQ/OQ サービス

オプションでIQ/OQドキュメントをご購入いただけます。
DeNovix社の認証を受けた株式会社スクラムの技術サービスがIQ/OQ作業を実施し、レポートを提出いたします。
- Installation Qualification(IQ)
- Operational Qualification(OQ)
ドキュメント内容の詳細については弊社までお問い合わせください。
21 CFR Part11
CellDropシリーズのEasy Apps ソフトウェアは、オプションのアクチベーションコードをご購入いただくことで、21 CFR Part11に準拠したオペレーションが可能です。
- アクセスのパスワード保護とユーザーアカウント管理
- 電子署名コントロール
- 監査証跡
- データ管理とエクスポート管理
製品仕様
![]() CellDrop BF / BFx |
![]() CellDrop FLi / FLxi |
|
| 測定チャンネル | 明視野 |
明視野 シングル蛍光 デュアル蛍光 蛍光+明視野 |
| ダイナミックレンジ | BF & FLi:7 x 10²〜2.5 x 10⁷ BFx & FLxi:4.3 x 10³〜2.1 x 10⁸ |
|
| 細胞直径レンジ | 4 ~ 400 μm | |
| サンプル必要量 |
5 µL(チャンバー高:50 μm 時) 10 µL(チャンバー高:100 μm 時) 40 µL(チャンバー高:400 μm 時) |
|
| 測定時間 | 3秒(明視野 @ 1 x 106 cells/mL) |
3秒(明視野 @ 1 x 106 cells/mL) 8.5秒(蛍光 @ 1 x 106 cells/mL) |
| サンプル測定面の材質 | 光学サファイア | |
| 明視野光源 | 530 nm LED | |
| 蛍光光源 | ₋ | 470 nm LED |
| 蛍光検出波長 | ₋ |
530 ± 25 nm 645 ± 37 nm |
| 画像サイズ | 2590 x 1942 pixel | 2048 x 1536 pixel |
| フォーカス調整 | 自動 / マニュアル | |
| 接続 | Wi-Fi, Ethernet, HDMI, USB | |
| 内蔵ストレージ | 120 GB SSD(1 TBにアップグレード可) | |
| ディスプレイ | 7インチカラー液晶タッチパネル | |
| オプション | バーコードリーダー、キーボード、マウス | |
| 装置サイズ | 幅21 x 奥行37 x 高さ18 cm | |
| 装置重量 | 4.4 kg | |
| 保証期間 | 2年間 | |
製品/シリーズに関するお問い合わせ
製品に関するご質問や技術的なお問い合わせなどはこちらのフォームをご利用ください。